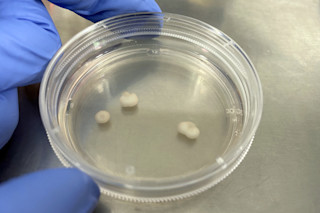

这个故事刊登在2020年6月刊上,原名为“Out of His Mind”。订阅《Discover》杂志,阅读更多此类故事。
作家菲利普·鲍尔并非每天都被邀请参与科学实验——通常情况下,他是在报道这些实验。但在2015年,伦敦的一个名为“Created Out of Mind”项目的科学家们邀请鲍尔和其他一些创意人士参与他们的工作,然后反思他们的体验。他同意了。
鲍尔首先提供了一个样本,由他的皮肤细胞组成,这些细胞被重新编程为干细胞,然后被培养成脑类器官——或者,如研究团队所称,一个微型“培养皿中的大脑”。这些听起来很科幻的标本并非真正的大脑,外形也不像。这些圆形的、奶油色的神经元簇看起来就像一团小小的糊状物。它们没有意识。但是,它们可以被用来更好地理解大脑发育——例如,某些蛋白质在哪里以及何时错误折叠,这可以指示一个人是否会患上痴呆症。

这张染色的显微镜图像显示了脑类器官横截面中正在生长的细胞,其中神经元显示为红色。(图片来源:Chris Lovejoy and Selina Wray)
Chris Lovejoy 和 Selina Wray
随后,研究人员要求鲍尔通过写作来反思他的经历。最初为“Created Out of Mind”撰写的一些博客,最终发展成了一本书,名为《How to Grow a Human》。在这里,鲍尔讲述了他与他的迷你大脑相处的时光,以及这个过程如何让他对实验室培育生命的未来有了新的认识。
亲述...
我时不时地会去实验室看看进展。有一次,我过去的时候,一位研究人员告诉我,这些类器官看起来不太好——因为某些原因,它们没有按照他们预想的那样生长。我们不确定它们最终会变成什么样子,最终很多类器官在完全形成之前就死亡了。

菲利普·鲍尔(图片来源:Richard Houghton)
Richard Houghton
但是有一天,出乎意料地,一位项目负责人给我发了一封邮件,附上了照片,并说:“看,这是你的迷你大脑。”它就那样在那里……我希望当时有些戏剧性的感觉,但研究人员对此相当淡然,因为他们一直在培养这些东西。我希望我能说我当时想着,“天哪,这是我的第二个大脑”,但我认为我当时更多的是一种如释重负的感觉,因为它真的长成了类器官。它们竟然得到了一个具有如此清晰、可辨别结构的器官,这相当了不起。如果说有什么感觉的话,那就是我对自己能最终创造出一些东西感到有点自豪。
对我来说,我从这个项目中获得的一个真正有趣的东西是,我们所组成的物质具有不可思议的多样性。将体内几乎任何其他组织的细胞转化的技术相对较新,它正在为医学和研究开辟各种方向。我亲眼看到细胞——即使是成熟的成年细胞——也具有非凡的能力,这让我着迷。